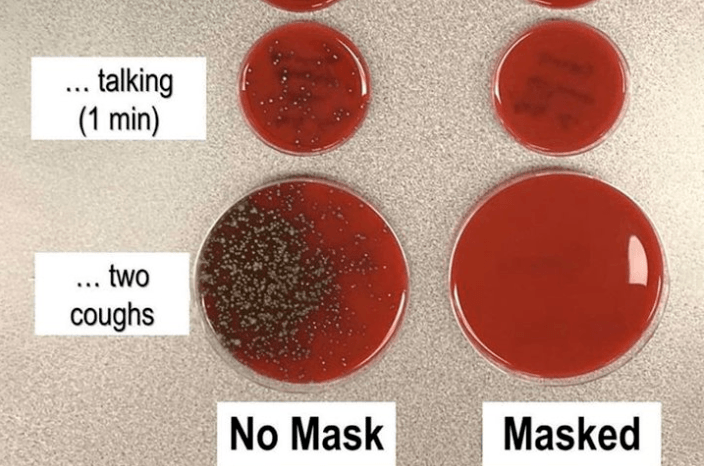
Wetenschapper toont met eenvoudig experiment aan hoe belangrijk mondmaskers zijn

Wetenschappers van de Universiteit Antwerpen (UA) hebben voor de vierde keer sinds de uitbraak van de corona-epidemie bloedstalen van landgenoten onderzocht op de aanwezigheid van antilichamen tegen het virus. Slechts 5,5% van de stalen bleek antilichamen te bevatten. Dat zijn er minder dan bij het vorige onderzoek, toen bijna 7% van de stalen antilichamen bevatte, zo berichten vrtnws.be en De Standaard.
De aanwezigheid van antilichamen in het bloed, wijst erop dat de persoon met het coronavirus besmet is geweest. De wetenschappers hebben voor hun meest recente onderzoek 2.960 stalen onderzocht van mensen die bloed hebben afgestaan tussen 8 en 13 juni.
De vorige drie onderzoeken dateren van voor en tijdens de lockdown. Het aantal bloedstalen dat antilichamen bevatte, ging toen in stijgende lijn: van bijna 3, over 6 tot bijna 7%. Bij het meest recente onderzoek daalt het aantal tot 5,5%.
1 à 2 maanden immuun
Professor Pierre Van Damme ziet twee mogelijke verklaringen voor de plotse daling: “Uit eerder onderzoek was al gebleken dat bij sommige mensen de antilichamen in het bloed al na 1 à 2 maanden afnemen. De kans bestaat dat er tussen de stalen die we nu onderzocht hebben, bloed zat van mensen bij wie de antilichamen al verdwenen waren, maar die dus wel ooit besmet zijn geweest.”
Een tweede verklaring is dat mensen zich goed aan de maatregelen houden (handen wassen, afstand bewaren) en dat ze dat ook blijven doen nu de lockdown versoepeld is. “Dat is positief nieuws, omdat er zo minder besmettingen bijkomen”, aldus epidemioloog Van Damme.
Het bericht Slechts 5,5% van Belgen heeft antilichamen in bloed verscheen eerst op Metro.